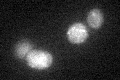
YGL136C

View description
Mitochondrial 2' O-ribose methyltransferase, required for methylation of U(2791) in 21S rRNA; MRM2 deletion confers thermosensitive respiration and loss of mitochondrial DNA; has similarity to Spb1p and Trm7p, and to E. coli FtsJ/RrmJ
Localization:
Intensity:
Fold change:
Significance:
-
C’ GFP library in SD

mitochondria20.28 -
N' NOP1pr-GFP in SD

mitochondria57.7736 -
N' TEF2pr-mCherry in SD

mitochondriaN/A -
N' NATIVEpr-GFP in SD

mitochondria17.8214 -
N' TEF2pr-VC and Cyto-VN in SD

#N/A0 -
C’ GFP library in SD+DTT
mitochondria18.860.93No -
C’ GFP library in SD+H2O2

mitochondria16.470.81No -
C’ GFP library in Starvation Media

mitochondria19.430.95No -
C’ GFP library on the background of Pup2-DaMP

mitochondria -
C’ GFP library on the background of CCT mutant

mitochondria18.90060.931626No
